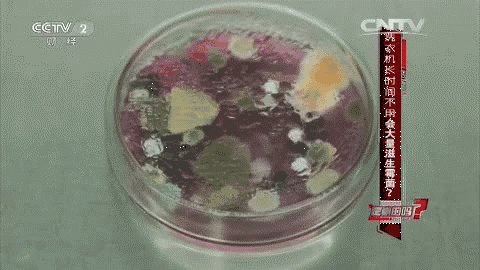

本文由未来医生官方推送
相信很多人都被教育过:内裤千万不能和袜子一起洗,不卫生!
然而,现实中还是有不少人为了节省时间和精力,会一股脑地把袜子和内裤混在一起洗。
这样方便是方便了,但袜子那么脏,会不会也把内裤也弄得不干净,导致私处得病呢?
答案是——有可能
一 有脚气的人,别再混洗了
什么疾病会通过袜子、内裤混洗的方式,把脚上的问题传染到自己的私密部位?
那就是「脚气」(也就是脚癣)。

患有脚气的人如果不将袜子和内裤分开来洗,就可能将导致脚气的红色毛癣菌等真菌传播到内裤上,从而造成「股癣」。
所以,袜子、内裤混洗会让私密处得病并非完全是危言耸听。
有脚气的人就别想着偷懒了,老老实实将内裤和袜子分开洗吧。
二 这些人群,也不建议混洗
要问穿过的袜子和内裤哪个脏,只能告诉你两者在伯仲之间。
据研究,每条穿过的内裤平均带有0.1克粪便,其中会含有甲肝病毒、轮状病毒、沙门氏菌及大肠杆菌等细菌和病毒。

而穿过袜子上主要有汗液、老旧角质、金黄色葡萄球菌、真菌等。
因此,为了防止两者「交叉感染」,如果有任何脚部、皮肤以及生殖器的相关疾病问题,又或者是抵抗力差的人,都不建议将内裤和袜子混洗。
说了那么多袜子和内裤不该混洗的情况,那些平常不注意的人也不必惶恐,如果你身体健康,且无相关疾病,二者混洗是不会有事的。
三 身体健康的人,混洗时得注意
由于人体的免疫系统有自我保护的能力,可以抵御大部分病原微生物,在身体健康的情况下接触到内裤、袜子上的病菌并没那么容易生病。

因此如果你没有上述所说疾病或者情况,是可以把内裤和袜子混洗的。
不过为了防范于未然——将贴身衣物的致病菌降低到最少,混洗时最好做到以下两点:
1、混洗内裤和袜子时使用含有「消毒成分」的洗衣液或者添加「消毒剂」。
2、洗完内裤和袜子后要记得及时晾干或者烘干,不给致病菌在上面繁殖的环境。
另外,还有一点也很关键,不要用长时间未清洁过的洗衣机洗内裤,因为你永远不知道这样的洗衣机有多脏!
四 慎用洗衣机洗内裤
人们会害怕袜子上的病菌传播到内裤上,却不知道长时间不清理的洗衣机才是最脏的。
洗衣机如果不及时清洗和消毒,很容易滋生「霉菌」的,特别容易影响抵抗力不强的孩子。
央视记者曾经做过实验:洗衣机的内桶跟外桶中间的夹层以及下水回路最容易藏污纳垢。
因此,如果洗衣机不能做到定时清理,是不建议清洗内裤的。
而洗衣机本身最好每3个月清洗一次。
总结:内裤和袜子分开来洗肯定没错,但如果你身体健康、抵抗力强且有条件及时晒干、晾干衣物,那么将二者混洗也没有问题。
图片来源于网络,如有侵权,联络删除。


